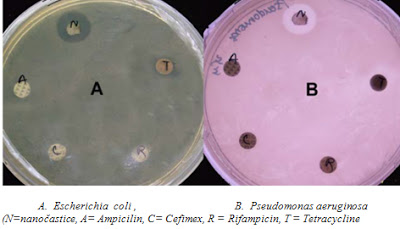

Ako pôsobí koloidné striebro na mikroorganizmy
Výskumom bolo zistené, že na mikrobiocídnu ativitu nanočastíc striebra vplývajú okrem koncentrácie dva hlavné faktory: veľkosť a tvar nanočastíc. Autori (12), (13) uvádzajú, že čím sú nanočastice striebra menšie tým sú mikrobiologicky účinnejšie (lepšie zabíjajú mikroorganizmy). Vplyv tvaru nanočastíc na ich mikrobiocídnu aktivitu skúmali autori (14), ktorí zistili, že aktivita nanočastíc stúpa s veľkosťou ich styčnej plochy s bunkovou membránou baktérie E. Coli.
Escherichia Coli Obr. č. 3

Na obrázku je názorne vidieť pôsobenie koloidného striebra o rozmeroch častíc 20 nm a koncentrácii 12 ppm na kolónie baktérie Escherichia Coli (v červenom rámčeku bez prídavku koloidného striebra, v ostatných s prídavkom). Po 5 minútach pôsobenia uhynulo 100% baktériíu všetkých označených vzoriek. (9)
Merania modernými analytickými metódami na vzorkách koloidného striebra ukázali na schopnosť nanočastíc a nanoklastrov uvoľňovať katióny striebra pri dostatočnej chemickej afinite reagentov a táto schopnosť rastie so zmenšovaním sa rozmerov častíc, zrejme v dôsledku stérických vplyvov v Sternovej vrstve.
Autori (14) sa domievajú, že bakteriálna bunka v kontakte s Ag-nanočasticou uvoľňuje a následne prijíma strieborné ióny, ktoré potom blokujú dýchacie enzýmy, spôsobujú generovanie reaktívnych kyslíkových radikálov a v dôsledku toho dochádza k poškodeniu bunky. Zároveň poškodenie membránovej morfológie môže spôsobiť významný vzrast permeability, vedúcej k neriadenému transportu cez plazmovú membránu a konečne, bunkovú smrť. Tento mechanizmus pôsobenia sa vzťahuje na elektrostaticky stabilizované iónové striebro IONT a má určité negatívne účinky aj na ľudské bunky. Merania, vykonané pomocou ESR (7) zas naznačujú radikálový mechanizmus pôsobenia.
Koloidné striebro ARGENA a UNIVERSAL nie je stabilizované elektrostaticky, teda nemá na povrchu nanočastíc strieborné katióny, ktoré zároveň poškodzujú ľudské bunky, ale reaguje v prvom rade s aminokyselinou cysteín v bunkovej membráne patogénu tak, ako to ukazuje obrázok č. 4.
Obr. č 4

Povrch baktérie E. coli napadnutý sférickými nanočasticami Ag (14)
Čierne body na snímke povrchu baktérie sú nanočastice Ag, ktoré spôsobujú deformáciu a následnú degradáciu bunkovej membrány. Striebro má tendenciu reagovať so slabými Lewisovými zásadami typu R-S-R, R-SH, RS-, alebo PR3. Takže proteíny s obsahom síry, nachádzajúce sa v membráne (cysteín), alebo vo vnútri bunky (N-formylmetionín) sú zrejme preferenčnými miestami pre väzby strieborných nanočastíc. Vďaka kovalenčnej väzbe dochádza postupne k mechanickému pretrhnutiu bunkovej steny a baktéria hynie.
Tab. 1: Výsledky testovania antimikrobiálnej aktivity nanočastíc striebra (10, 22)
(MIC - minimálna inhibičná koncentrácia nanočastíc striebra, GP-gram pozitívna baktéria, GN-gram negatívna baktéria)
Príklad antibakteriálnej aktivity nanočastíc striebra (koncentrácia 50 ppm), stanovenej metódou Kirby-Bauer na papierových diskoch a porovnanie s inými antibiotikami. Táto metóda využíva disky s jednotlivými koncentráciami antimikrobiálnych látok a priemery zón korelujú s minimálnymi inhibičnými koncentráciami (MIC) (16).
Obr. č. 5
Účinnosť koloidného striebra na reprezentačné typy baktérií pri testovaní komerčne vyrábaného deodorantu, obsahujúceho 200 ppm nanočastíc striebra (11).



Z tabuliek 1, 2, 3, a 4 vyplýva, že koloidné striebro najlepšie účinkuje na grampozitívne baktérie, ale aj mnohé gramnegatívne (napr. E.Coli) a takmer neúčinkuje na baktérie, ktoré sú schopné tvoriť za nepriaznivých podmienok spóry.
(Čísla v tabuľkách sú vyjadrené v jednotkách CFU - počte životaschopných baktérií.)
Bohužiaľ, autori (20) zistili, že situácia v oblasti účinkov koloidného striebra na mikroorganizmy je zložitejšia, čo dokladujú výsledkami v tab. 5.
Tab. 5:

Z klinického prostredia pripravili izoláty zlatého stafylokoka (MSSA) a metycilín rezistentného zlatého stafylokoka (MRSA) a ako referenčnú vzorku použili S. aureus ATCC25923 a zisťovali hodnoty minimálnej inhibičnej (MIC) a bakteriocídnej (MBC) koncentrácie. Výsledky ukazujú, že na rôzne izoláty je efektivita pôsobenia koloidného striebra rôzna. Preto sa aj výsledky praktického použitia koloidného striebra u rovnakého druhu patogénu často odlišujú.
Z tohto dôvodu potom autori práce (36) mohli určiť nasledovné rastové krivky E. coli a S. aureus (rozmer nanočastíc 10 - 15 nm) :

čo je v rozpore s údajmi tabuliek č.1 a 2., podľa ktorých je S. aureus veľmi citlivý na pôsobenie koloidného striebra. Podobná situácia je zrejme i u mnohých ďalších mikroorganizmov.

Dynamická rastová krivka S. aureus ATCC 25923 (a) a MRSA (b) v prítomnosti rôznych koncentrácií koloidného striebra. (MRSA-methycillín-rezistentný S. aureus ; μg/ml = ppm) podľa autorov (19).
Je vidieť, že koncentrácia už 20-25ppm prakticky zastavuje rast obidvoch kmeňov, predstavuje pre ne teda rovnakú minimálnu inhibičnú koncentráciu MIC, bez ohľadu na to, či je kmeň rezistentný, alebo nie. Podobné účinky uvádzajú aj autori (20) pre E. Coli.

Striebro rezistentné baktérie: (22)
Nanočastice striebra sú tiež skúmané ako potencionálne antivirotikum (23), (24), kde sa predpokladá interakcia s gp120 glykoproteínom- konkrétne väzba na tiolové skupiny cysteínu.
Obr. č. 6

Obrázok vírusu HIV-1 zasiahnutého nanočasticami Ag (23)
Významné inhibičné účinky boli zistené na Monkeypox víruse, víruse opičích kiahní (30). nAg koncentrácie 25 ppm účinne inhibuje apoptózu MDCK buniek, vyvolanú chrípkovým vírusom H3N2 (31). Nanočastice striebra môžu inhibovať produkciu RNA vírusu hepatitídy B a extracelulárnych viriónov (32), inhibovať vírus Herpes Simplex Typ 1 (33). Bohužiaľ autori (24) zistili že u kmeňov arenavírusov, ako napr. Tacaribe vírus k inhibícii vírusu musí dôjsť počas začiatku replikácie, pretože aj keď pred ňou liečba infekcie s nanočasticami striebra je veľmi účinná, po jej zahájení je účinná iba v prípade podania počas prvých 2-4 hodín.
Výsledky testovania fungicídnej aktivity koloidného striebra na kvasinkách a plesniach Candida species a Trichophyton mentagrophytes (15).

Z tabuľky 5 vyplýva, že koloidné striebro sa aktivitou približuje prípravku Amphotericin B, ale značne prekonáva účinky prípravku Fluconazole, je teda perspektívnym a účinným antimykotikom. (IC80 je inhibičná koncentrácia 80% kultúry plesne).